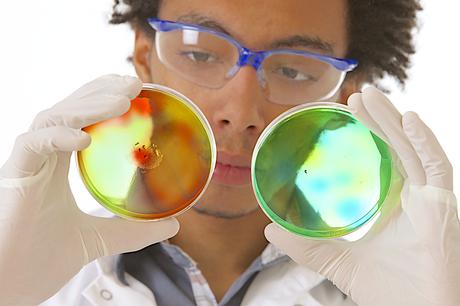
On apprécie de mieux en mieux le rôle clé du microbiome intestinal dans notre santé et à vie. Mais comment se forme-t-il exactement ? (Visuel Adobe Stock 53717225)

On apprécie de mieux en mieux le rôle clé du microbiome intestinal dans notre santé et à vie. Mais comment se forme-t-il exactement ? Cette équipe du Carnegie Institution for Science (Washington) a regardé si la composition de notre microbiome intestinal était le fruit du hasard et, le cas échéant, quels étaient les facteurs qui pouvaient, dès la naissance, contribuer à le façonner. Ces travaux, présentés dans les Actes de l’Académie des Sciences américaine (PNAS), révèlent des indices cruciaux sur la façon dont les communautés bactériennes qui composent chacun de nos microbiomes intestinaux individuels sont acquises. Avec des implications majeures pour les traitements tels que les transplantations de microbiote fécal et l'administration de probiotiques.
Le microbiome intestinal est un écosystème de centaines à des milliers d'espèces microbiennes vivant dans le corps humain. Ces populations affectent notre santé, notre fertilité et même notre longévité. « Il existe une énorme variation dans la composition du microbiome entre les individus », explique l’auteur principal, William B. Ludington, biologiste à la John Hopkins (Baltimore) : « Si vous considérez la globalité des espèces bactériennes adaptées pour vivre dans le système gastro-intestinal des humains, la plupart d'entre elles ne sont pas présentes chez la majorité des gens. Ces populations microbiennes intestinales sont incroyablement diverses ».
Expliquer la diversité et la variabilité du microbiome
De multiples facteurs sont évoqués pour expliquer ces différences, d’un individu à l’autre, ou plutôt une combinaison de plusieurs d’entre eux, associés à la génétique, l'alimentation et l'environnement. Cependant, dans ces travaux, les scientifiques soulignent
cette dose de hasard en jeu chaque fois que nous sommes exposés à un nouveau microbe.
Ce microbe sera-t-il acquis et deviendra-t-il un membre de notre écosystème intestinal ? Quels sont les facteurs déterminants de cette acquisition ?
Mieux comprendre le processus de colonisation : peu de recherches ont encore été entreprises dans le cadre d’un environnement contrôlé pour mieux comprendre le processus par lequel de nouvelles espèces rejoignent avec succès l'écosystème microbien de l'intestin. L’équipe a donc dû développer un nouveau modèle écologique pour comprendre comment nous acquérons cette configuration de communautés microbiennes, spécifique à chacun.
In vivo : le microbiome comparativement beaucoup moins complexe des mouches des fruits permet ici à l'équipe de démontrer que l'exposition à une espèce microbienne ne garantit pas son incorporation réussie dans l'écosystème du microbiome. En réalité, l'état du microbiome et les interactions entre les espèces préexistantes du microbiome définissent la probabilité « d’accueillir » ou pas une nouvelle espèce bactérienne. Ainsi, chez des mouches génétiquement identiques qui vivent dans le même espace et sont nourries avec le même régime alimentaire, les scientifiques observent de grandes variations dans la composition du microbiome.
In silico : les scientifiques ont donc développé des modèles mathématiques pour tester des scénarii de plus en plus complexes par lesquels de nouvelles espèces peuvent être acquises, ce qui leur a permis de mieux cerner les facteurs communautaires qui conditionnent l'appartenance d’une espèce à l'écosystème du microbiome.
« Une grande fête durant laquelle certains invités partent tôt et d’autres restent après l’aube »,
La colonisation bactérienne dépend d'un certain nombre de facteurs complexes que les scientifiques commencent tout juste à comprendre :
- certains groupes d'espèces facilitent la colonisation des autres et certaines espèces sont donc plus susceptibles de coexister ;
- les interactions entre différentes communautés bactériennes ont des implications sur la façon dont les microbiomes sont transmis entre individus et sur les moyens de moduler le microbiome d'une personne de manière à lui conférer une composition souhaitée ;
- finalement, la colonisation est un lancer de dés, mais pondéré par des interactions biologiques, et associée à une base moléculaire affinée par l'évolution.
Optimiser et personnaliser les thérapies qui ciblent le microbiote intestinal : En résumé, les scientifiques aboutissent à de premiers modèles mathématiques complexes qui peuvent permettre aussi d’optimiser conditions de succès des thérapies qui ciblent aujourd’hui la composition du microbiote, dont les transplantations fécales et les probiotiques. Avec une ébauche de transition des thérapies « microbiotiques » vers une médecine personnalisée du microbiome.
Source: Proceedings of the National Academy of Sciences (PNAS) 8 Feb, 2022 DOI: 10.1073/pnas.2115877119 Stochastic microbiome assembly depends on context
Plus sur Microbiote Blog
Équipe de rédaction SantélogMar 6, 2022Rédaction Santé log
